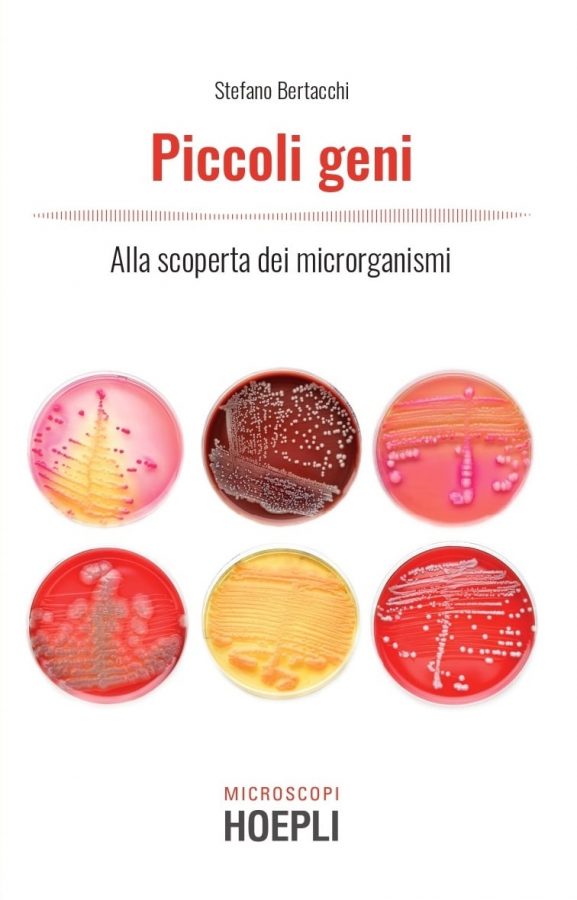
libri da leggere a marzo

Argomenti trattati
La primavera sta arrivando e non c’è niente di meglio che aspettarla immergendosi nella lettura. Ecco i libri da non perdere a marzo 2021.
Libri da leggere a marzo
Thriller, libri di divulgazione, racconti di storie appassionanti. Tra i libri più interessanti da leggere nel mese di marzo 2021 ci sono moltissime novità che placheranno la sete di conoscenza di moltissimi.
Aspettando la primavera, non c’è nulla di meglio che perdersi nella lettura di un buon libro accarezzati dal tiepido sole immergendosi nella natura.
Ecco quindi i titoli a cui non si può rinunciare. In particolar modo, i libri di Michela Murgia e di Rula Jebreal sono irrinunciabili per il mese della Festa della donna.
Stai zitta
Stai zitta è il libro scritto da Michela Murgia, autrice del best seller Accabadora. Mette in evidenza il legame che esiste tra le ingiustizie che si vivono e le parole che si sentono. Le parole, in Italia, hanno nei confronti della donna un potere enorme, ricco di ingiustizie e luoghi comuni, intriso di maschilismo. Ecco quindi che ci si rifiuta di chiamare sindaca, avvocata, architetta, non si viene chiamate per cognome, ci si sente dire di stare zitta, di scopare di più, di calmarsi. Si tratta di un impianto maschilista sostenuto da una struttura verbale che lo giustifica. Tutto questo è spiegato nel libro della Murgia che si preannuncia un altro best seller.

2119 la disfatta dei sapiens
Romanzo d’esordio per Sabina Guzzanti. Nel 2119 la situazione sulla Terra e critica, ma un gruppo di eroi sta lottando per salvare il futuro. Dopo catastrofi ambientali e pandemie, chi è sopravvissuto è stato costretto a sottostare a un regime ingiusto, ispirato al feudalesimo. La società è formata da pochi milioni di ricchissimi onnipotenti e miliardi di migranti ambientali raggruppati in centri d’accoglienza, senza diritto di voto. Si tratta di un romanzo che tratta temi di estrema attualità in una realtà distopica: dal cambiamento climatico alle pandemie, dalla concentrazione della ricchezza alla dipendenza dalla tecnologia.

Later
Nuovo romanzo per il famsissimo autore Stephen King. Later racconta di Jamie Conklin, figlio di una madre single in difficoltà, vuole solo un’infanzia normale. Ma Jamie non è un ragazzino qualunque. Nato con una dote innaturale che sua madre lo costringe a mantenere segreta, Jamie vede e fa cose che gli altri non possono. Ma il costo dell’uso di questo potere è più alto di quanto Jamie immagini, quando scopre che la compagna della madre, una detective di New York, lo coinvolge nella caccia a un assassino.

Il cambiamento che meritiamo
Abbiamo conosciuto la giornalista Rula Jebreal sul palco di Sanremo 2020. Autrice, scrittrice palestinese con cittadinanza italiana e israeliana ha realizzato il suo nuovo libro: Il cambiamento che meritiamo. Come le donne stanno tracciando la strada verso il futuro. Nel mondo una donna su tre è vittima di abusi ogni giorno e quotidianamente vengono assassinate più di cento donne da uomini che dicono di amarle. Serve intervenire prima che tutta questa violenza destabilizzi, con enormi ripercussioni fisiche e psicologiche sulle prossime generazioni. Nella sua opera la Jebreal racconta la storia di sua madre Nadia, vittima di uomini, a cui affianca le voci di altre donne sopravvissute, pronte a gridare al mondo ciò che hanno subito.

Il caso Agresti
Le gemelle Agresti, in arte Alisja e Irina, sono state due ballerine famose per le loro esibizioni televisive e per la loro straordinaria somiglianza: una sola la differenza, il colore dei capelli. Già da qualche anno la loro fama si sta offuscando, quando una delle due viene ritrovata in mare al largo di Ischia, forse annegata, sicuramente sfigurata nel tentativo di renderla irriconoscibile. Quando l’altra, Alisja, si presenta nel suo studio, Max Gilardi vive ancora da solo, e si trova suo malgrado trascinato in un caso dove a fare da filo conduttore è l’ambiguità delle persone e dei sentimenti, e al di sotto del quale si spalanca un mondo in cui confluiscono malaffare, traffici illegali, sesso a pagamento e stupefacenti. Elda Lanza ci riporta indietro nel tempo, a un Gilardi forse ancora inesperto ma sicuramente già geniale nella capacità di vedere prima di chiunque altro cose che nessuno oserebbe neppure immaginare.

La sarta di Parigi
La sarta di Parigi è un romanzo storico di Georgia Kaufman, ispirato alle vicende capitate alla madre e alla nonna dell’autrice. Siamo a New York nel 1991, dove Rosa Kusstatscher ha costruito un impero della moda. Una sera, mentre si prepara per l’incontro più importante della sua vita riaffiora la sua insicurezza. Scegliendo cosa indossare ripercorre la sua storia: una ragazza di montagna del Sud Tirolo, che ha vissuto l’occupazione nazista, a cui è sfuggita scappando dall’Italia di notte. Prima in Svizzera, poi a Parigi, a Rio de Janeiro e infine a New York.

Spin
Nuovo romanzo della super autrice Patricia Cornwell. Spin è un thriller che racconta le vicende di un’investigatrice. Aiutata da tecnologie all’avanguardia, l’investigatrice scienziata della NASA e pilota della Space Force dovrà a ogni costo scoprire l’anello mancante che lega il sabotaggio del razzo a quello che le sta accadendo. Una ricerca che qualcuno sembra intenzionato a fermare a ogni costo.

Piccoli geni – Alla scoperta dei microrganismo
Un libro divulgativo realizzato da Stefano Bertacchi, in cui si parla del microcosmo di batteri e microorganismi che popolano la Terra con noi. Tra lieviti, muffe, batteri, c’è un mondo tutto da scoprire. Dal fondo dell’oceano alle nuvole, dall’Antartide alla macchina del caffè, i microrganismi hanno colonizzato moltissimi habitat e sono fondamentali per la vita sulla Terra. Questi esseri si muovono, mangiano e persino cacciano, si fanno la guerra, ma allo stesso tempo collaborano tra di loro e anche con esseri viventi ben più grandi, quali noi umani ricoperti e pieni di microrganismi come siamo, letteralmente dalla testa ai piedi.
La pelle lo sa
Altro libro divulgativo, realizzato dai dermatologi Alessandro Martella e Federica Osti. In un mondo quasi ossessionato dalla skincare e dal benessere della pelle, i due professionisti raccontano a fondo i segreti di quest’organi che ci fa da involucro. Un libro da aver per i curiosi e gli appassionati del sapere.




